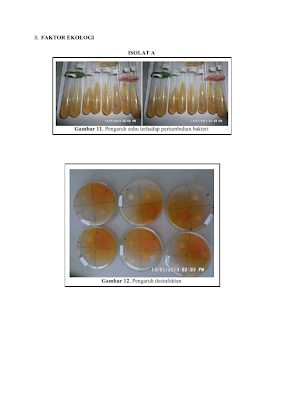

udah lama gak posting, nanti awal kuliah janji bakalan nulis terus...... :) kali ini aku postingan ku terinspirasi ketika aku menulis essay buat apply Universitas Paramadina well, aku lolos buat thap aplikasi tapi sayangnya tahap wawancara gak bisa aku ikutin karna alhamdulillah aku keterima di salah satu universitas ternama di Indonesia. alhamdulillahi rabbil 'alamin. inspirasi datang jam 12 teng-tengah malem, mulai deh aku ambil kertas, pena, dan.... jreng2.... mari menulis.. :) "bingung""?????" pertama mau nulis, aku ingin jadi psikolog? yeah...cita-cita ku dimulai ketika aku kelas satu SMA. but now, check it out... aku mlah keterima di jurusan mikrobiologi. it's okay gak papa, yg penting univ nya nyangkut di Universitas Gajah Masa Indonesia. yeeee..yeee..... aku bahagia....aku gembira.....bisa masuk kesana... :) :) :) but, cita-cita ku gak pudar buat jadi seorang psikolog, do'ain S2 bisa ke jurusan psikologi. aminn. udah ah, ntar...
Menulis menjadi sebuah peristiwa yang menegangkan tetapi indah dan sakral. (Putu Wijaya)

Comments
Post a Comment